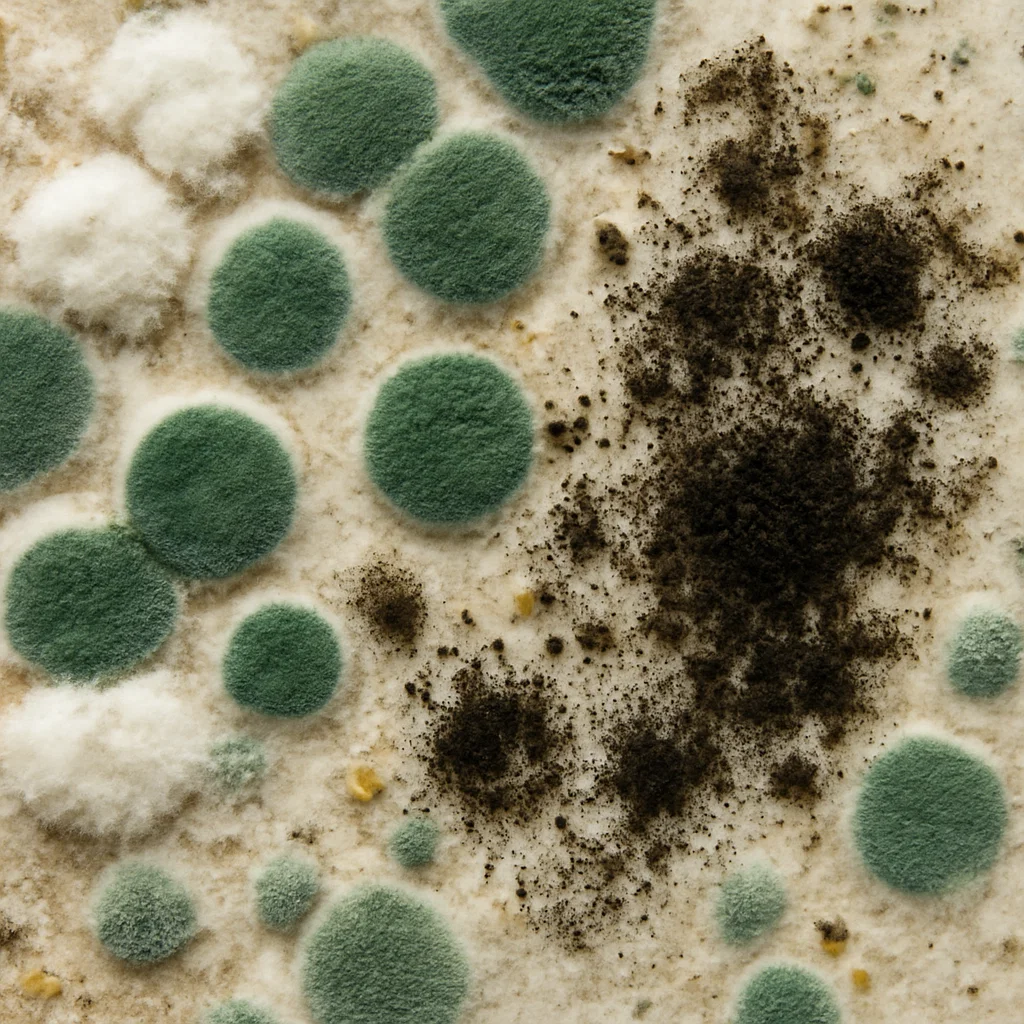
کپک جزیی از پاتوژن های فاضلاب

پاتوژنهای خطرناک فاضلاب | شناسایی قبل از بحران
روشهای نوین شناسایی آلایندههای میکروبی و پاتوژنهای قارچی در فاضلاب چیست؟
پاتوژنهای قارچی فاضلاب به گروهی از قارچها گفته میشود که میتوانند در محیطهای مرطوب و غنی از مواد آلیِ فاضلاب رشد کرده و برای سلامت انسان یا سایر موجودات زنده مشکلساز شوند. قارچها موجوداتی یوکاریوتی هستند؛ یعنی سلولهای آنها دارای هسته مشخص بوده و برخلاف گیاهان، قابلیت فتوسنتز ندارند. این ارگانیسمها معمولاً در شرایط هوازی رشد میکنند و انرژی لازم برای بقا و تکثیر خود را از اکسیداسیون مواد آلی موجود در محیط به دست میآورند.
فرایند تکثیر قارچها میتواند جنسی یا غیرجنسی باشد و بسته به گونه، از طریق تشکیل اسپور، جوانهزنی یا تقسیم سلولی انجام میشود. حضور این پاتوژنها در فاضلاب اهمیت زیادی دارد؛ زیرا برخی از آنها میتوانند سبب مشکلاتی مانند آلرژی، عفونتهای پوستی، بیماریهای تنفسی یا آلودگی زیستمحیطی شوند. به همین دلیل شناسایی، پایش و کنترل آنها در سیستمهای تصفیه فاضلاب نقش مهمی در مدیریت بهداشت محیط و حفاظت از سلامت جامعه دارد.
انواع پاتوژن های قارچی چیست؟
قارچ ها در سه دسته ی زیر قرار می گیرند:
- مخمرها
- کپک ها
- شبه مخمرها
-
مخمرها:
مخمرها قارچهایی تکسلولی و فاقد ساختار رشتهای هستند و عمدتاً از طریق جوانهزنی تکثیر میشوند. این دسته از قارچها به دلیل توانایی متابولیزهکردن قند، در بسیاری از صنایع مانند نانوایی، تخمیر، تقطیر و آبجوسازی نقش مهمی دارند.
- در شرایط بیهوازی: قند را تبدیل به الکل کرده و مقدار کمی سلول جدید تولید میکنند.
- در شرایط هوازی: بیشتر به سمت تولید سلول جدید میروند و الکل تولید نمیشود.
کلنیهای مخمری معمولاً ظاهری خامهای یا بلغمی داشته و بافتی بسیار نرم دارند. حضور برخی گونههای مخمری در فاضلاب میتواند عامل آلودگی یا بروز بیماریهای فرصتطلب در انسان باشد.
-
کپک ها:
کپکها قارچهایی رشتهای، چندسلولی، غیر فتوسنتتیک و هتروتروف هستند که اغلب در شرایط هوازی رشد میکنند. ساختار آنها از واحدهایی به نام هایفا تشکیل شده است که در کنار یکدیگر میسیلیوم را بهوجود میآورند. کپکها معمولاً در محیطهای اسیدی و غنی از قند بهترین رشد را دارند و رشد آنها غالباً روی سطوح مواد غذایی پوسیده مانند میوههای فاسد مشاهده میشود.
کلنی کپکها میتواند طیفی از رنگها مانند سفید، آبی، سبز، خاکستری یا بنفش داشته باشد. برخی از کپکها در فاضلاب میتوانند پاتوژن باشند و بیماریهایی مانند آلرژی، عفونتهای تنفسی یا مشکلات پوستی ایجاد کنند.
-
شبه مخمرها:
شبهمخمرها دارای سلولهایی کروی یا بیضوی هستند که پس از جوانهزدن، بهصورت سست به سلول مادر متصل میمانند و با تداوم رشد، زنجیرههایی شبیه به رشتههای میسیلیومی ایجاد میکنند؛ به همین دلیل به آنها مخمرهای دارای میسیلیوم کاذب گفته میشود. این گروه نیز میتواند در محیطهای مرطوب و غنی از مواد آلی فاضلاب رشد کند و برخی گونههای آن دارای پتانسیل بیماریزایی هستند، بهویژه در افرادی با سیستم ایمنی ضعیف.
محیط های کشت برای جدا کردن قارچ ها
برای شناسایی و جداسازی قارچها، از محیطهای کشت مختلفی استفاده میشود. بیشتر این محیطها برای رشد انواع قارچها مناسب هستند و نمونهها، بهجز نمونههای مو، ناخن و پوست، معمولاً در ظرفهای مخصوص کشت قرار داده میشوند. در بسیاری از محیطهای کشت قارچی، از مواد بازدارنده استفاده میشود تا از رشد میکروبهای ناخواسته جلوگیری شود و شرایط برای رشد قارچها مناسبتر گردد.
برای آگاهی بیشتر به مقاله “بررسی جامع انواع میکروب، عوامل بیماری زا و پاتوژن ” مراجعه کنید.
بهطور کلی، محیطهای کشت قارچها به دو دسته تقسیم میشوند:
- محیطهای معمولی
- محیطهای اختصاصی
برخی از محیطهایی که برای بررسی و جداسازی قارچها به کار میروند شامل انواع محیطهای مبتنی بر مواد مغذی، محیطهای غنیشده و محیطهایی هستند که برای مشاهده ویژگیهای خاص قارچها طراحی شدهاند.
در جدول زیر، محیط های کشت مختلف برای پاتوژن ها را ببنید:
| نوع محیط کشت | کاربرد کلی | ویژگیها / توضیحات |
|---|---|---|
| محیطهای معمولی | رشد عمومی انواع قارچها | برای بسیاری از نمونهها استفاده میشود؛ اغلب همراه با مواد بازدارنده جهت جلوگیری از رشد باکتریها. |
| محیطهای اختصاصی | بررسی دقیقتر گونههای قارچی یا ویژگیهای خاص | مناسب برای مشاهده رفتار، شکلگیری ساختارها یا محدود کردن رشد سایر میکروبها. |
| سابورو دکستروز آگار (SDA) | رشد عمومی قارچها | محیطی غنی از قند که برای بیشتر قارچها مناسب است. |
| سابورو دکستروز آگار + مواد بازدارنده | افزایش انتخابپذیری محیط | وجود موادی مانند کلرامفنیکل و سیکلوهگزامید از رشد برخی میکروبها و قارچهای ناخواسته جلوگیری میکند. |
| محیط عصاره مغز و قلب | رشد قارچها و برخی میکروارگانیسمهای نیازمند مواد مغذی بیشتر | حاوی ترکیبات مغذی برای رشد قویتر. |
| محیط خوندار | کشت ارگانیسمهای حساستر | محیط غنیشده برای بررسی کلنیهای مشخص و رشد بهتر برخی موجودات. |
| کورن میل آگار (CMA) | مشاهده ویژگیهای ظاهری و ساختاری قارچها | برای بررسی خصوصیات فنوتیپی و مورفولوژیک برخی گونهها کاربرد دارد. |
شرایط زنده ماندن و رشد پاتوژنهای قارچی در فاضلاب چیست؟
عوامل بسیاری پاتوژنهای قارچی توانایی بالایی برای بقا در شرایط سخت محیطی دارند، از جمله:
-
نیازهای محیطی
- رطوبت کم: قارچها حتی در محیطهایی با رطوبت محدود نیز میتوانند رشد کنند.
- مقاومت نسبت به pH پایین: بسیاری از گونهها در pH اسیدی نیز زنده میمانند.
- pH مناسب رشد: حدود 6.5 برای اکثر گونهها شرایط ایدهآل است.
- دامنه تحمل pH: معمولاً بین ۲ تا ۹.
- نیاز کم به نیتروژن: مقدار نیتروژن لازم برای قارچها تقریباً نصف مقدار مورد نیاز باکتریهاست.
۲. اهمیت ویژگیهای قارچها در تصفیه فاضلاب
توانایی قارچها در رشد در pH پایین و کمبود نیتروژن باعث میشود در برخی بخشهای سیستمهای تصفیه نقش مهمی داشته باشند:
- کمک به تصفیه بیولوژیکی فاضلابهای صنعتی خاص
- نقش مؤثر در فرایند کمپوست مواد آلی جامد
- حضور غالب قارچهای رشتهای در صافیهای چکنده و لجن فعال
- تأثیر این قارچها در پدیده حجیم شدن لجن و مشکلات مرحله زلالسازی
۳. شرایط تشدید رشد پاتوژنهای قارچی
پاتوژنهای قارچی در فاضلابهایی با شرایط زیر رشد بیشتری نشان میدهند:
- pH پایین
- وجود مقدار زیاد کربوهیدراتها
برای مدیریت رشد بیشازحد این قارچها، معمولاً بهصورت عمومی از مواد قلیایی برای افزایش pH استفاده میشود.
۴. روشهای عمومی شناسایی قارچها
شناسایی قارچها در سطح توصیفی معمولاً بر اساس:
- شکل کلنی
- نوع تقسیم سلولی
- ویژگیهای ظاهری و مورفولوژیک
همچنین شناسایی مخمرها معمولاً بر پایه ویژگیهای فیزیولوژیکی انجام میشود.
۵. شمارش کلنیها در آزمایشگاه
در بررسی نمونهها، هر کلنی قارچی بهعنوان یک واحد تشکیلدهنده کلنی (CFU) در نظر گرفته میشود؛ این واحد میتواند از یک سلول یا چند سلول تشکیل شده باشد. وجود مقدار زیاد برخی گونههای قارچی معمولاً نشاندهنده آلودگی آب است.
انواع روش های شمارش قارچ ها و آلاینده های میکروبی فاضلاب
روش های مختلف شمارش پاتوژن قارچی به شرح زیر است:
- میکروبیولوژی آب، روش های شمارش، رنگ سنجی و فلورمتری
- روش های ایمونولوژیک
- روش های ژنتیکی
- توالی یاب توالییابی DNA
- طیف سنجی جرمی
- ریزآرایه ها
- روش های فیزیکی
میکروبیولوژی آب، روش های شمارش، رنگ سنجی و فلورمتری
تست HPC (تعداد استاندارد صفحات) به طور گسترده ای برای اندازه گیری آلاینده های میکروبی از جمله میکروارگانیسم های هتروتروف، که به منبع خارجی کربن آلی برای رشد نیاز دارند، در آب آشامیدنی به کار می رود.
-
روش های ایمونولوژیک برای تشخیص آلاینده های میکروبی
روشهای مبتنی بر آنتیبادی (Ab) از قرابتهای اتصال ویژه Abs به آنتیژنهای خاص بهره میبرند. پس از تولید و آزمایش از نظر ویژگی، Abs معمولاً بر روی یک سیستم پشتیبانی (تکیههای نایلونی، کنسولها، مهرههای مغناطیسی، پلاستیک و غیره) نصب می گردند.
-
روش های ژنتیکی برای تشخیص پاتوژن قارچی
این رویکردها بر تمایل توالیهای اسید نوکلئیک خاص به «ماهیگیری» برای دنباله مکمل مورد علاقه تکیه میکنند و به این روشها اجازه میدهند بسیار خاص باشند. متداولترین تکنیکها بر اساس روشهای واکنش زنجیرهای پلیمراز (PCR)، تقویت اسید نوکلئیک همدما یا ریزآرایهها هستند.
-
توالی یاب توالییابی DNA برای تشخیص پاتوژن قارچی
جایگزینی برای شناساییهای معمول در سطح گونهها است. توالی های DNA را می توان به راحتی به دست آورد و برای شناسایی پاتوژن های قارچی بسیار دقیق است.
-
طیف سنجی جرمی برای شمارش آلاینده های میکروبی
ایده اصلی شناسایی میکروارگانیسم ها با تجزیه و تحلیل طیف سنجی جرمی پروتئین ها از دهه 1970 سرچشمه می گیرد. این یک ویژگی فیزیکی ذاتی، نسبت جرم به بار یک آنالیت را تشخیص میدهد که منجر به تجزیه و تحلیلهای قوی و دقیق میشود. تنوع میکروبی محیطی را می توان با بررسی های جامع پروتئومی مقایسه ای در نظر گرفت که در آن هزاران پروتئین شناسایی و اندازه گیری می شوند.
-
ریزآرایه ها
ریزآرایه یک آزمایشگاه چندگانه روی یک تراشه است که مقادیر زیادی از مواد بیولوژیکی را با استفاده از روشهای غربالگری با کارایی بالا ارزیابی میکند. مفهوم و روش ریزآرایه ها برای اولین بار در ریزآرایه های آنتی بادی در سال 1983 معرفی شد. همانطور که صنعت تراشه ژندر دهه 1990 شروع به رشد کرد، فناوری ریزآرایه های DNA به پیچیده ترین و پرکاربردترین تبدیل شد.
-
روش های فیزیکی برای تشخیص پاتوژن قارچی فاضلاب
برای تشخیص پاتوژنهای قارچی فاضلاب، از روشهای فیزیکی مدرن مانند طیفسنجی مادون قرمز، طیفسنجی رامان و طیفسنجی شکست ناشی از لیزر استفاده میشود. این تکنیکها امکان شناسایی سریع و دقیق ساختار مولکولی و ترکیبات زیستی قارچها را فراهم کرده و در پایش بهداشتی و کنترل کیفیت آب نقش مهمی ایفا میکنند.
کلام آخر:
مدیریت صحیح منابع آب ارتباط مستقیم با سلامت انسان دارد، زیرا آب در مصارف مختلفی از جمله آشامیدن، بهداشت و صنایع مورد استفاده قرار میگیرد. بیماریهای عفونی منتقله از طریق آب، چه ناشی از عوامل طبیعی و چه آلودگی عمدی، اهمیت ویژهای دارند و میتوانند سلامت عمومی را بهطور جدی تهدید کنند. برای پیشگیری از شیوع گسترده این بیماریها، شناسایی سریع آلایندههای میکروبی و بیولوژیکی ضروری است. این اقدام به تعیین محدوده امنیتی، هشدار به مردم و آمادهسازی خدمات بهداشتی برای اقدامات پیشگیرانه کمک میکند. صنایع آرال شیمی با معرفی محلول ضدعفونیکننده اگوسیب، محصول مورد تایید سازمان FDA، به مبارزه با پاتوژنهای قارچی موجود در فاضلاب میپردازد.
⇐ بروز رسانی شده در آذر ماه 1404
-
اگوسیب | ضدعفونی کننده فاضلاب صنعتی
محدوده قیمت: 1012000تومان تا 1897500تومان انتخاب گزینهها این محصول دارای انواع مختلفی می باشد. گزینه ها ممکن است در صفحه محصول انتخاب شوند -
جرماسید | ضدعفونی کننده آماده بمصرف
محدوده قیمت: 325000تومان تا 1100000تومان انتخاب گزینهها این محصول دارای انواع مختلفی می باشد. گزینه ها ممکن است در صفحه محصول انتخاب شوند -
شوینده اسیدی بدون کف
محدوده قیمت: 2225000تومان تا 8500000تومان انتخاب گزینهها این محصول دارای انواع مختلفی می باشد. گزینه ها ممکن است در صفحه محصول انتخاب شوند -
شوینده قلیایی بدون کف
محدوده قیمت: 660000تومان تا 2200000تومان انتخاب گزینهها این محصول دارای انواع مختلفی می باشد. گزینه ها ممکن است در صفحه محصول انتخاب شوند